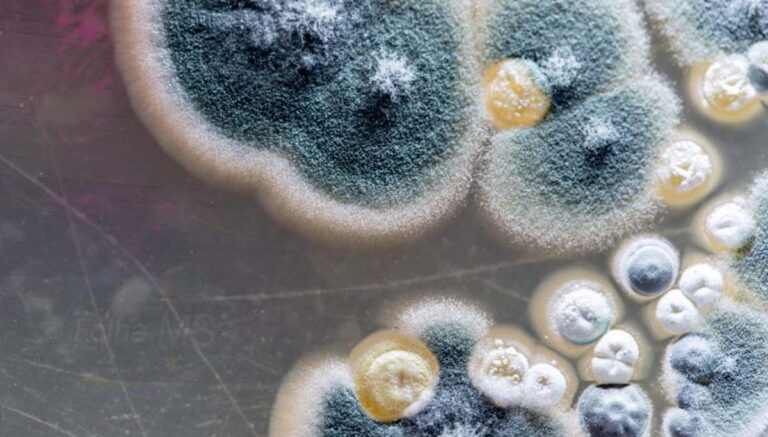
Suspeita de “fungo negro” em paciente de Corumbá não foi descartada
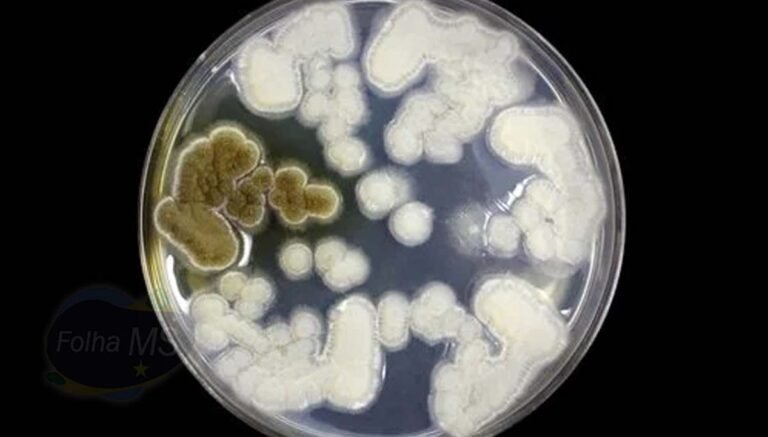
Saúde descarta suspeita de contaminação por “fungo negro” em paciente de Corumbá

PM recupera motocicleta roubada, prende autor e apreende arma de fogo
Além da prisão e recuperação do veículo, a PM apreendeu uma pistola calibre 9 milímetros com 13 munições usada no crime

Além da prisão e recuperação do veículo, a PM apreendeu uma pistola calibre 9 milímetros com 13 munições usada no crime

Colisão ocorreu na rua Sete de Setembro com Maranhão

Vítima caiu enquanto rebocava uma parede

Sem ferimentos, animal foi solto em uma área de vegetação nativa junto ao rio Paraguai

Das 14 vítimas fatais, 8 tinham menos de 60 anos e 7 não possuíam sequer comorbidades relatadas

Aos policiais homem contou que ateou fogo para acabar com os insetos no local

Caso ocorreu na noite deste domingo na área central de Corumbá
A suspeita recai sobre um paciente de 50 anos de idade, internado no Centro de Tratamento Intensivo da Santa Casa de Corumbá após, desenvolver sintomas graves da contaminação pelo novo Coronavírus

A perícia encontrou capsulas de pelo menos três calibres diferentes, entre eles de fuzil 5.56.
Suspeita de contaminação em paciente de 50 anos diagnosticado com covid-19 em Corumbá foi descartada